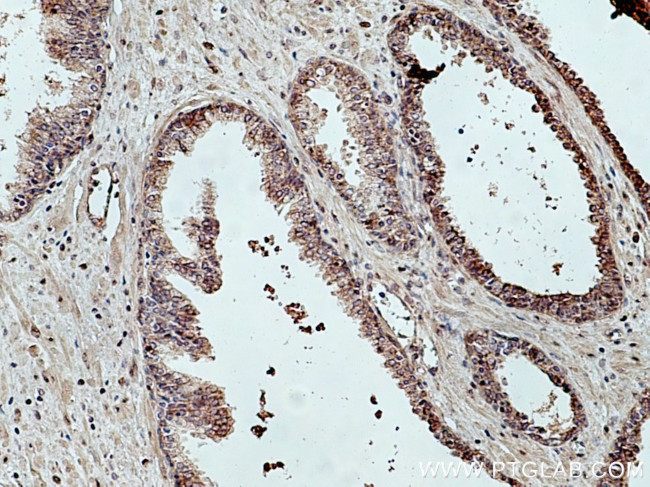
TBCE Antibody in Immunohistochemistry (Paraffin) (IHC (P))

Search
Proteintech
TBCE Polyclonal Antibody
{{$productOrderCtrl.translations['antibody.pdp.commerceCard.promotion.promotions']}}
{{$productOrderCtrl.translations['antibody.pdp.commerceCard.promotion.viewpromo']}}
{{$productOrderCtrl.translations['antibody.pdp.commerceCard.promotion.promocode']}}: {{promo.promoCode}} {{promo.promoTitle}} {{promo.promoDescription}}. {{$productOrderCtrl.translations['antibody.pdp.commerceCard.promotion.learnmore']}}
产品信息
12021-1-AP
种属反应
已发表种属
宿主/亚型
分类
类型
抗原
偶联物
形式
浓度
规格
纯化类型
保存液
内含物
保存条件
运输条件
产品详细信息
Immunogen sequence: MSDTLTADV IGRRVEVNGE HATVRFAGVV PPVAGPWLGV EWDNPERGKH DGSHEGTVYF KCRHPTGGSF IRPNKVNFGT DFLTAIKNRY VLEDGPEEDR KEQIVTIGNK PVETIGFDSI MKQQSQLSKL QEVSLRNCAV SCAGEKGGVA EACPNIRKVD LSKNLLSSWD EVIHIADQLR HLEVLNVSEN KLKFPSGSVL TGTLSVLKVL VLNQTGITWA EVLRCVAGCP GLEELYLESN NIFISERPTD VLQTVKLLDL SSNQLIDENQ LYLIAHLPRL EQLILSDTGI SSLHFPDAGI GCKTSMFPSL KYLVVNDNQI SQWSFFNELE K (1-330 aa encoded by BC008654)
靶标信息
Cofactor E is one of four proteins (cofactors A, D, E, and C) involved in the pathway leading to correctly folded beta-tubulin from folding intermediates. Cofactors A and D are believed to play a role in capturing and stabilizing beta-tubulin intermediates in a quasi-native confirmation. Cofactor E binds to the cofactor D/beta-tubulin complex; interaction with cofactor C then causes the release of beta-tubulin polypeptides that are committed to the native state.
仅用于科研。不用于诊断过程。未经明确授权不得转售。
生物信息学
蛋白别名: Tubulin-folding cofactor E; Tubulin-specific chaperone E; unnamed protein product
基因别名: 2610206D02Rik; C530005D02Rik; HRD; KCS; KCS1; pac2; PEAMO; pmn; TBCE
UniProt ID: (Human) Q15813, (Rat) Q5FVQ9, (Mouse) Q8CIV8
Entrez Gene ID: (Human) 6905, (Rat) 361255, (Mouse) 70430